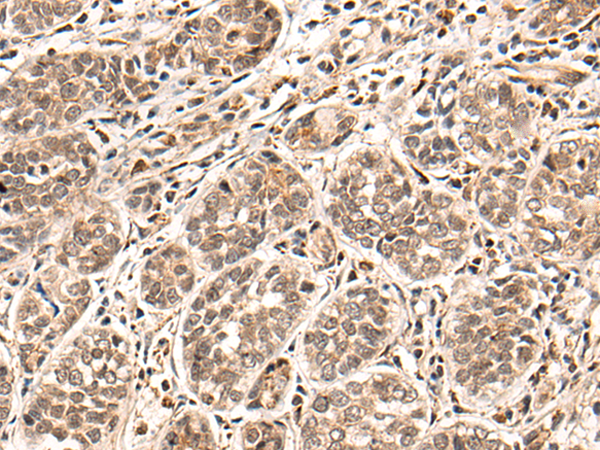

中文名稱: 兔抗HGH1多克隆抗體
英文名稱: Anti-HGH1 rabbit polyclonal antibody
別 名: BRP16; BRP16L; FAM203A; FAM203B; C8orf30A; C8orf30B
抗 原: HGH1
儲 存: 冷凍(-20℃)
宿 主: Rabbit
反應(yīng)種屬: Human
相關(guān)類別: 一抗
標(biāo) 記 物: Unconjugate
技術(shù)規(guī)格
|
Background: |
HGH1, is also known as BRP16, Brp16 is a 256 amino acid protein encoded by a gene on human chromosome 8. Made up of nearly 146 million bases, chromosome 8 encodes about 800 genes. Translocation of portions of chromosome 8 with amplifications of the c-Myc gene are found in some leukemias and lymphomas, and typically associated with a poor prognosis. Portions of chromosome 8 have been linked to schizophrenia and bipolar disorder. Trisomy 8, also known as Warkany syndrome 2, most often results in early miscarriage but is occasionally seen in a mosaic form in surviving patients who suffer to a varying degree from a number of symptoms including retarded mental and motor development, and certain facial and developmental defects. WRN is a DNA helicase encoded by chromosome 8 and shown defective in those with the early aging disorder Werner syndrome. Chromosome 8 is also associated with Pfeiffer syndrome, congenital hypothyroidism and Waardenburg syndrome. |
|
Applications: |
ELISA, IHC |
|
Name of antibody: |
HGH1 |
|
Immunogen: |
Synthetic peptide of human HGH1 |
|
Full name: |
HGH1 homolog |
|
Synonyms: |
BRP16; BRP16L; FAM203A; FAM203B; C8orf30A; C8orf30B |
|
SwissProt: |
Q9BTY7 |
|
ELISA Recommended dilution: |
5000-10000 |
|
IHC positive control: |
Human esophagus cancer |
|
IHC Recommend dilution: |
30-150 |

購物車
購物車 幫助
幫助
 021-54845833/15800441009
021-54845833/15800441009
